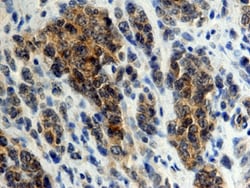
Human DC-SIGN+DC-SIGNR Antibody, R D Systems:Antibodies:Primary Antibodies

missing translation for 'onlineSavingsMsg'
Learn More
Learn More
Human DC-SIGN+DC-SIGNR Antibody, R&D Systems™


Mouse Monoclonal Antibody has been used in 8 publications
257.00€ - 2445.00€
Specifica
| Antigene | DC-SIGN+DC-SIGNR |
|---|---|
| Clone | 120612 |
| Concentrazione | LYOPH |
| Diluizione | Flow Cytometry 2.5 ug/10^6 cells, Immunohistochemistry 8-25 ug/mL, CyTOF-ready |
| Applicazioni | Flow Cytometry, Immunohistochemistry, CyTOF |
| Codice del prodotto | Marca | Quantità | Prezzo | Quantità e disponibilità | |||||
|---|---|---|---|---|---|---|---|---|---|
| Codice del prodotto | Marca | Quantità | Prezzo | Quantità e disponibilità | |||||
18792247
 |
R&D Systems
MAB1621-SP |
25 μg |
257.00€
25µg |
Effettua il login per acquistare questo articolo Hai bisogno di un conto web ? Registrati oggi stesso! | |||||
18758749
 |
R&D Systems
MAB1621-100 |
100 μg |
610.00€
100µg |
Effettua il login per acquistare questo articolo Hai bisogno di un conto web ? Registrati oggi stesso! | |||||
18710618
 |
R&D Systems
MAB1621-500 |
500 μg |
2445.00€
500µg |
Effettua il login per acquistare questo articolo Hai bisogno di un conto web ? Registrati oggi stesso! | |||||
Descrizione
DC-SIGN+DC-SIGNR Monoclonal specifically detects DC-SIGN+DC-SIGNR in Human samples. It is validated for Flow Cytometry, Immunohistochemistry, CyTOF-ready.Specifica
| DC-SIGN+DC-SIGNR | |
| LYOPH | |
| Flow Cytometry, Immunohistochemistry, CyTOF | |
| Unconjugated | |
| RUO | |
| Lyophilized from a 0.2 μm filtered solution in PBS with Trehalose. *Small pack size (SP) is supplied as a 0.2 μm filtered solution in PBS. with No Preservative | |
| 30835 | |
| NIH-3T3 mouse embryonic fibroblast cell line transfected with human DC-SIGNR Accession # Q9H2X3 | |
| Primary | |
| Reconstitute at 0.5 mg/mL in sterile PBS. | |
| Recognizes both human DC-SIGN and human DC-SIGNR on transfected cells. Does not react with parental mouse cells or irrelevant transfectants. |
| 120612 | |
| Flow Cytometry 2.5 ug/10^6 cells, Immunohistochemistry 8-25 ug/mL, CyTOF-ready | |
| Monoclonal | |
| Mouse | |
| Human | |
| Q9H2X3 | |
| CD209 | |
| IgG2a | |
| Protein A or G purified from hybridoma culture supernatant | |
| Use a manual defrost freezer and avoid repeated freeze-thaw cycles. 12 months from date of receipt, -20 to -70 degreesC as supplied. 1 month, 2 to 8 degreesC under sterile conditions after reconstitution. 6 months, -20 to -70 degreesC under sterile conditions after reconstitution. |
For Research Use Only
Individuate un'opportunità di miglioramento?Condividi una correzione di contenuto
Correzione del contenuto del prodotto
Fornite il vostro feedback sul contenuto del prodotto compilando il modulo sottostante.
Titolo del prodotto